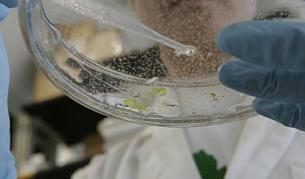
Връзка между Омега-3 и рак на простатата

Наука и техника

Изчезват ли традиционните занаяти
04.05.2011
През май "Нашънъл джеографик" помества още разкази за младото поколение дръзки катерачи в парка Йосемити

Жените по-умни, мъжете по-решителни
04.05.2011
Ако доскоро едни от големите спорове между представители на силния и нежния пол бяха кой е по-умен или кой взима по-лесно решенията, сега...

Хората с големи носове са склонни да лъжат
03.05.2011

Робот просяк събира помощи
03.05.2011
Роботи са новата конкуренция в борбата за оцеляване на улицата. Те обаче няма да молят за монети за лична нужда, а за да помагат на деца

Нов маршрут за космически туристи: До Луната и назад
03.05.2011
ри полета туристите ще наблюдават кратерите на лунната повърхност, планините и другите лунни забележителности от височина 100 км

Връщат дубликат на предполагаеми останки от Йети в манастир в Непал
02.05.2011
Оригиналният скалп и ръка на непознато същество били откраднати преди време от обителта
Връзка между Омега-3 и рак
01.05.2011
Смятахме, че е точно обратното, че тези мастни киселини помагат срещу прогресирането на рака, признават учените

Carnival Magic - гигантски круизен лайнер от Fincantieri
01.05.2011
На борда на плавателния съд е предвидено място за 4684 пасажера

Учените по пътя към точното прогнозиране на екологични катастрофи
30.04.2011
Ново проучване подпомага откриването на ранни белези за дестабилизация на една екосистема

Снимка на НЛО, летяло над Азърбайджан
30.04.2011
Загадъчният предмет напомнял по форма на типична летяща чиния

Откриха един от изчезналите градове на маите
28.04.2011

"Ходя като заспал" е вярно
28.04.2011







